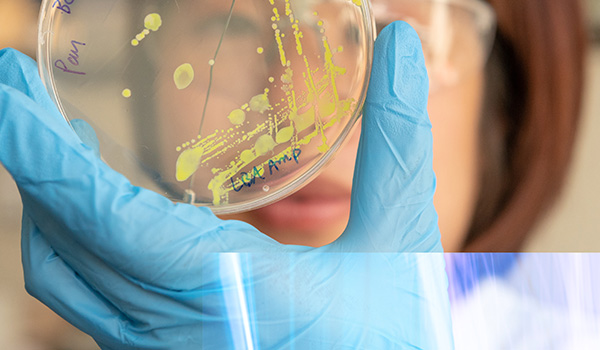

Set the Pace
What's in this video?
A visual series capturing the character and atmosphere of our campus through carefully framed decorative imagery. Architectural details, open spaces, natural light, and quiet moments of daily life combine to reflect a place shaped by purpose and community. Each frame documents the environment that supports learning, collaboration, and progress. The text reads "Together we will set the pace".
Together, we will Set the Pace.
Our goal with Set the Pace is bold.
Through your support, we will raise £250 million and generate 20,000 acts of volunteering by 2030.
Warwick has always been different. For 60 years, we have intentionally stood apart, reached further, and dared to do what others do not. Now, our momentum is at a tipping point. We are ready to make global impact fairer, faster, and greater than ever before.
With your support, we will challenge convention, forge more breakthroughs, shift thinking, and reshape tomorrow’s leaders for powerful change. Together, we will Set the Pace of Novel Energy, Fair and Sustainable Business, the Warwick Student Experience, Critical Arts, Peace Making, and Health Equity.
This is Warwick’s call to Set the Pace.

Professor Stuart Croft, Vice-Chancellor and President:
“Across our 60 years, Warwick has never been afraid to challenge convention. Our restless spirit means we outpace older, more established institutions through innovation, world-leading research, and outstanding teaching.
“Warwick is poised to deepen its global impact, widen participation, and unlock our research potential to help overcome these major challenges.
“Warwick was built on a foundation of philanthropy, and Set the Pace marks the next defining moment in our story, accelerating our ambition to point the way ahead, so that together we can make a better world.”